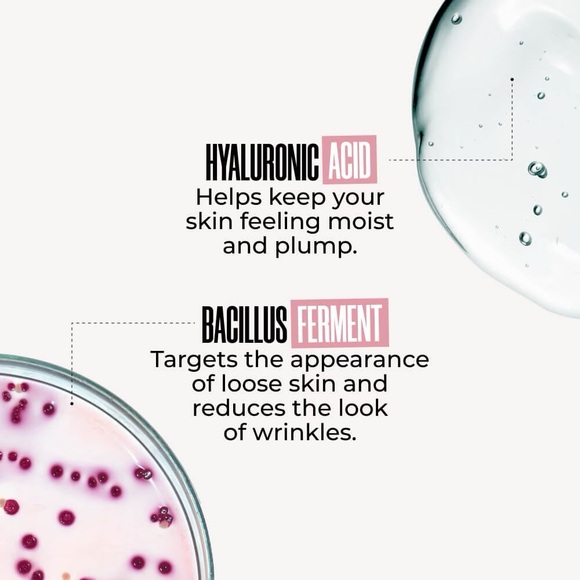
NEW SEALED Maelys Re-Solve Age Defying Body Serum ~ 3.5 oz - Picture 3 of 12

NEW SEALED Maelys Re-Solve Age Defying Body Serum ~ 3.5 oz
NWT
$43 $69
Pay in 4 interest-free payments of $10.75
with .
Learn More
.
Size
Like and save for later
Add To Bundle
Our most technologically advanced formula yet! Powered by Hyaluronic Fusion™ technology, this clinically proven body serum helps to:
Improve the appearance of fine lines and wrinkles
Target the appearance of loose skin
Strengthen your skin barrier
Maximize efficacy
Our super lightweight texture absorbs quickly, with no sticky after-feel. 100 g / 3.5 Oz.
Our formulas go through rigorous clinical trials conducted on panels of real women. The trial found that RE-SOLVE is:
Clinically proven to improve the look of wrinkles on the skin.
Clinically proven to improve the look of crepey skin.
Clinically proven to visibly hydrate the skin.
👀Follow me for more fabulous products! I add daily and give bundle discounts! Come check out my closet🥰
Shipping/Discount

hisprincess9086
likes this
Trending Now
Find Similar Listings
Account is under Review
Comment posting is temporarily restricted. Our team will reach out to you shortly. To understand why, select
Learn More.